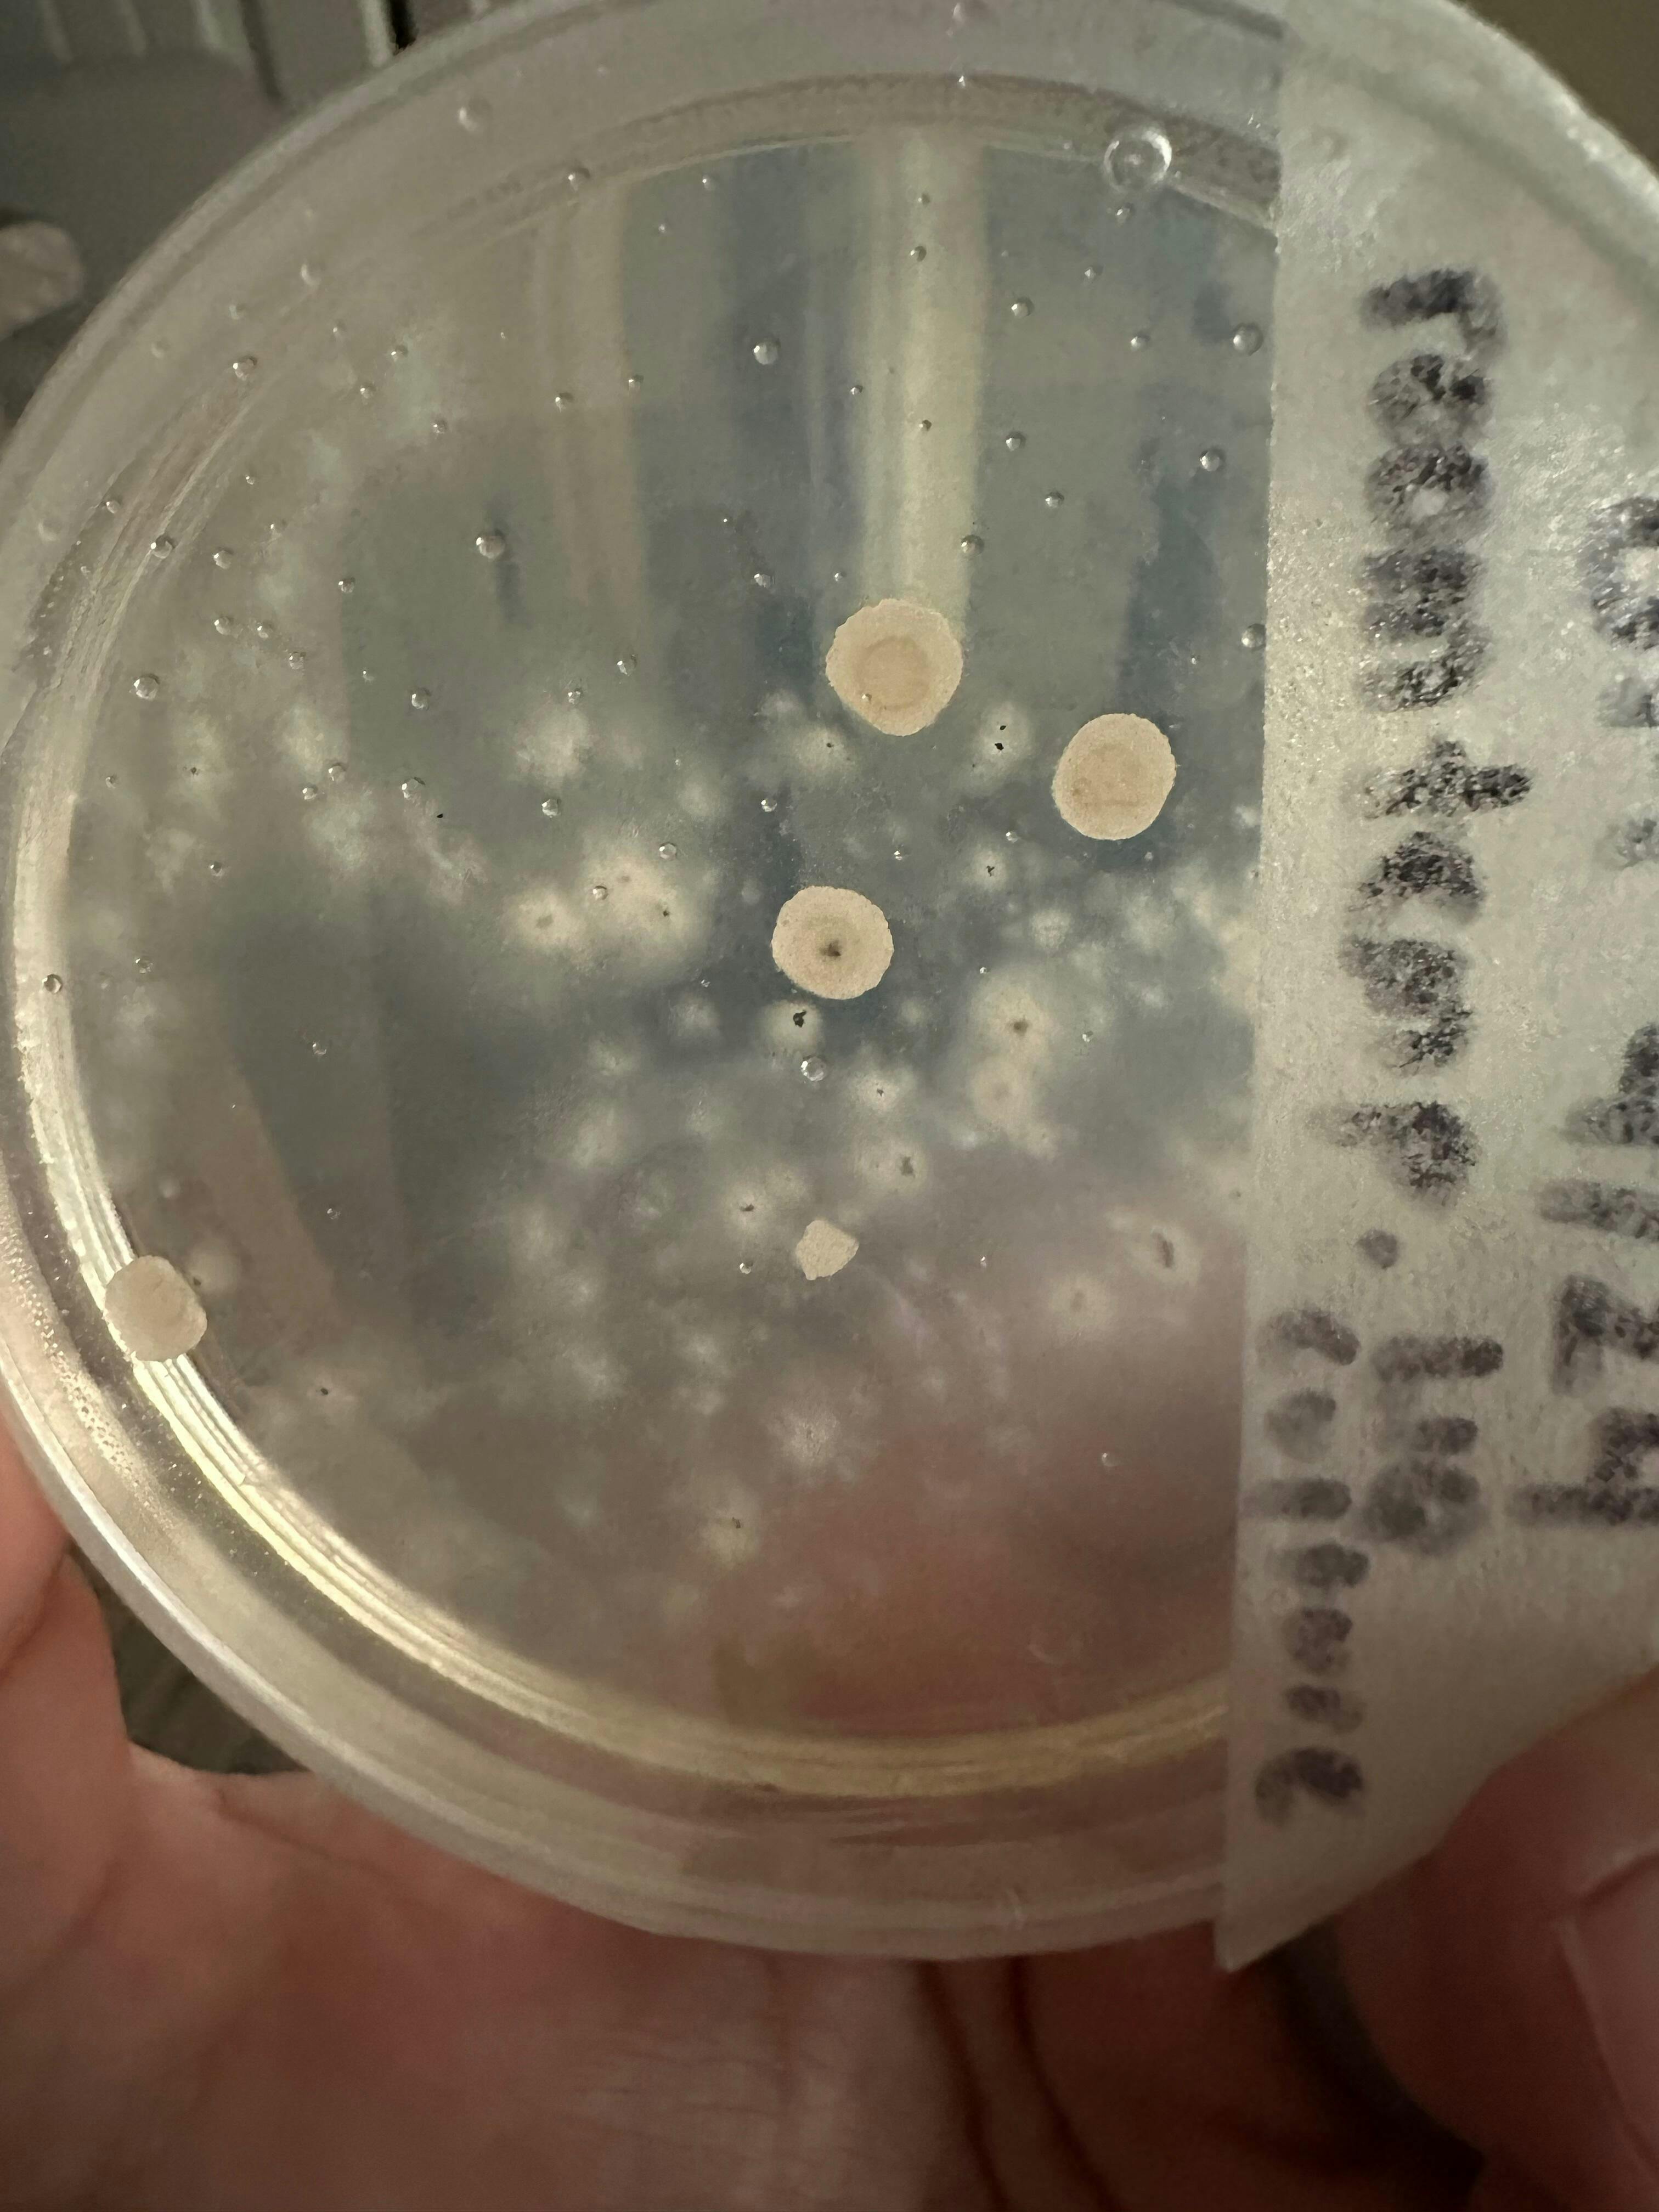
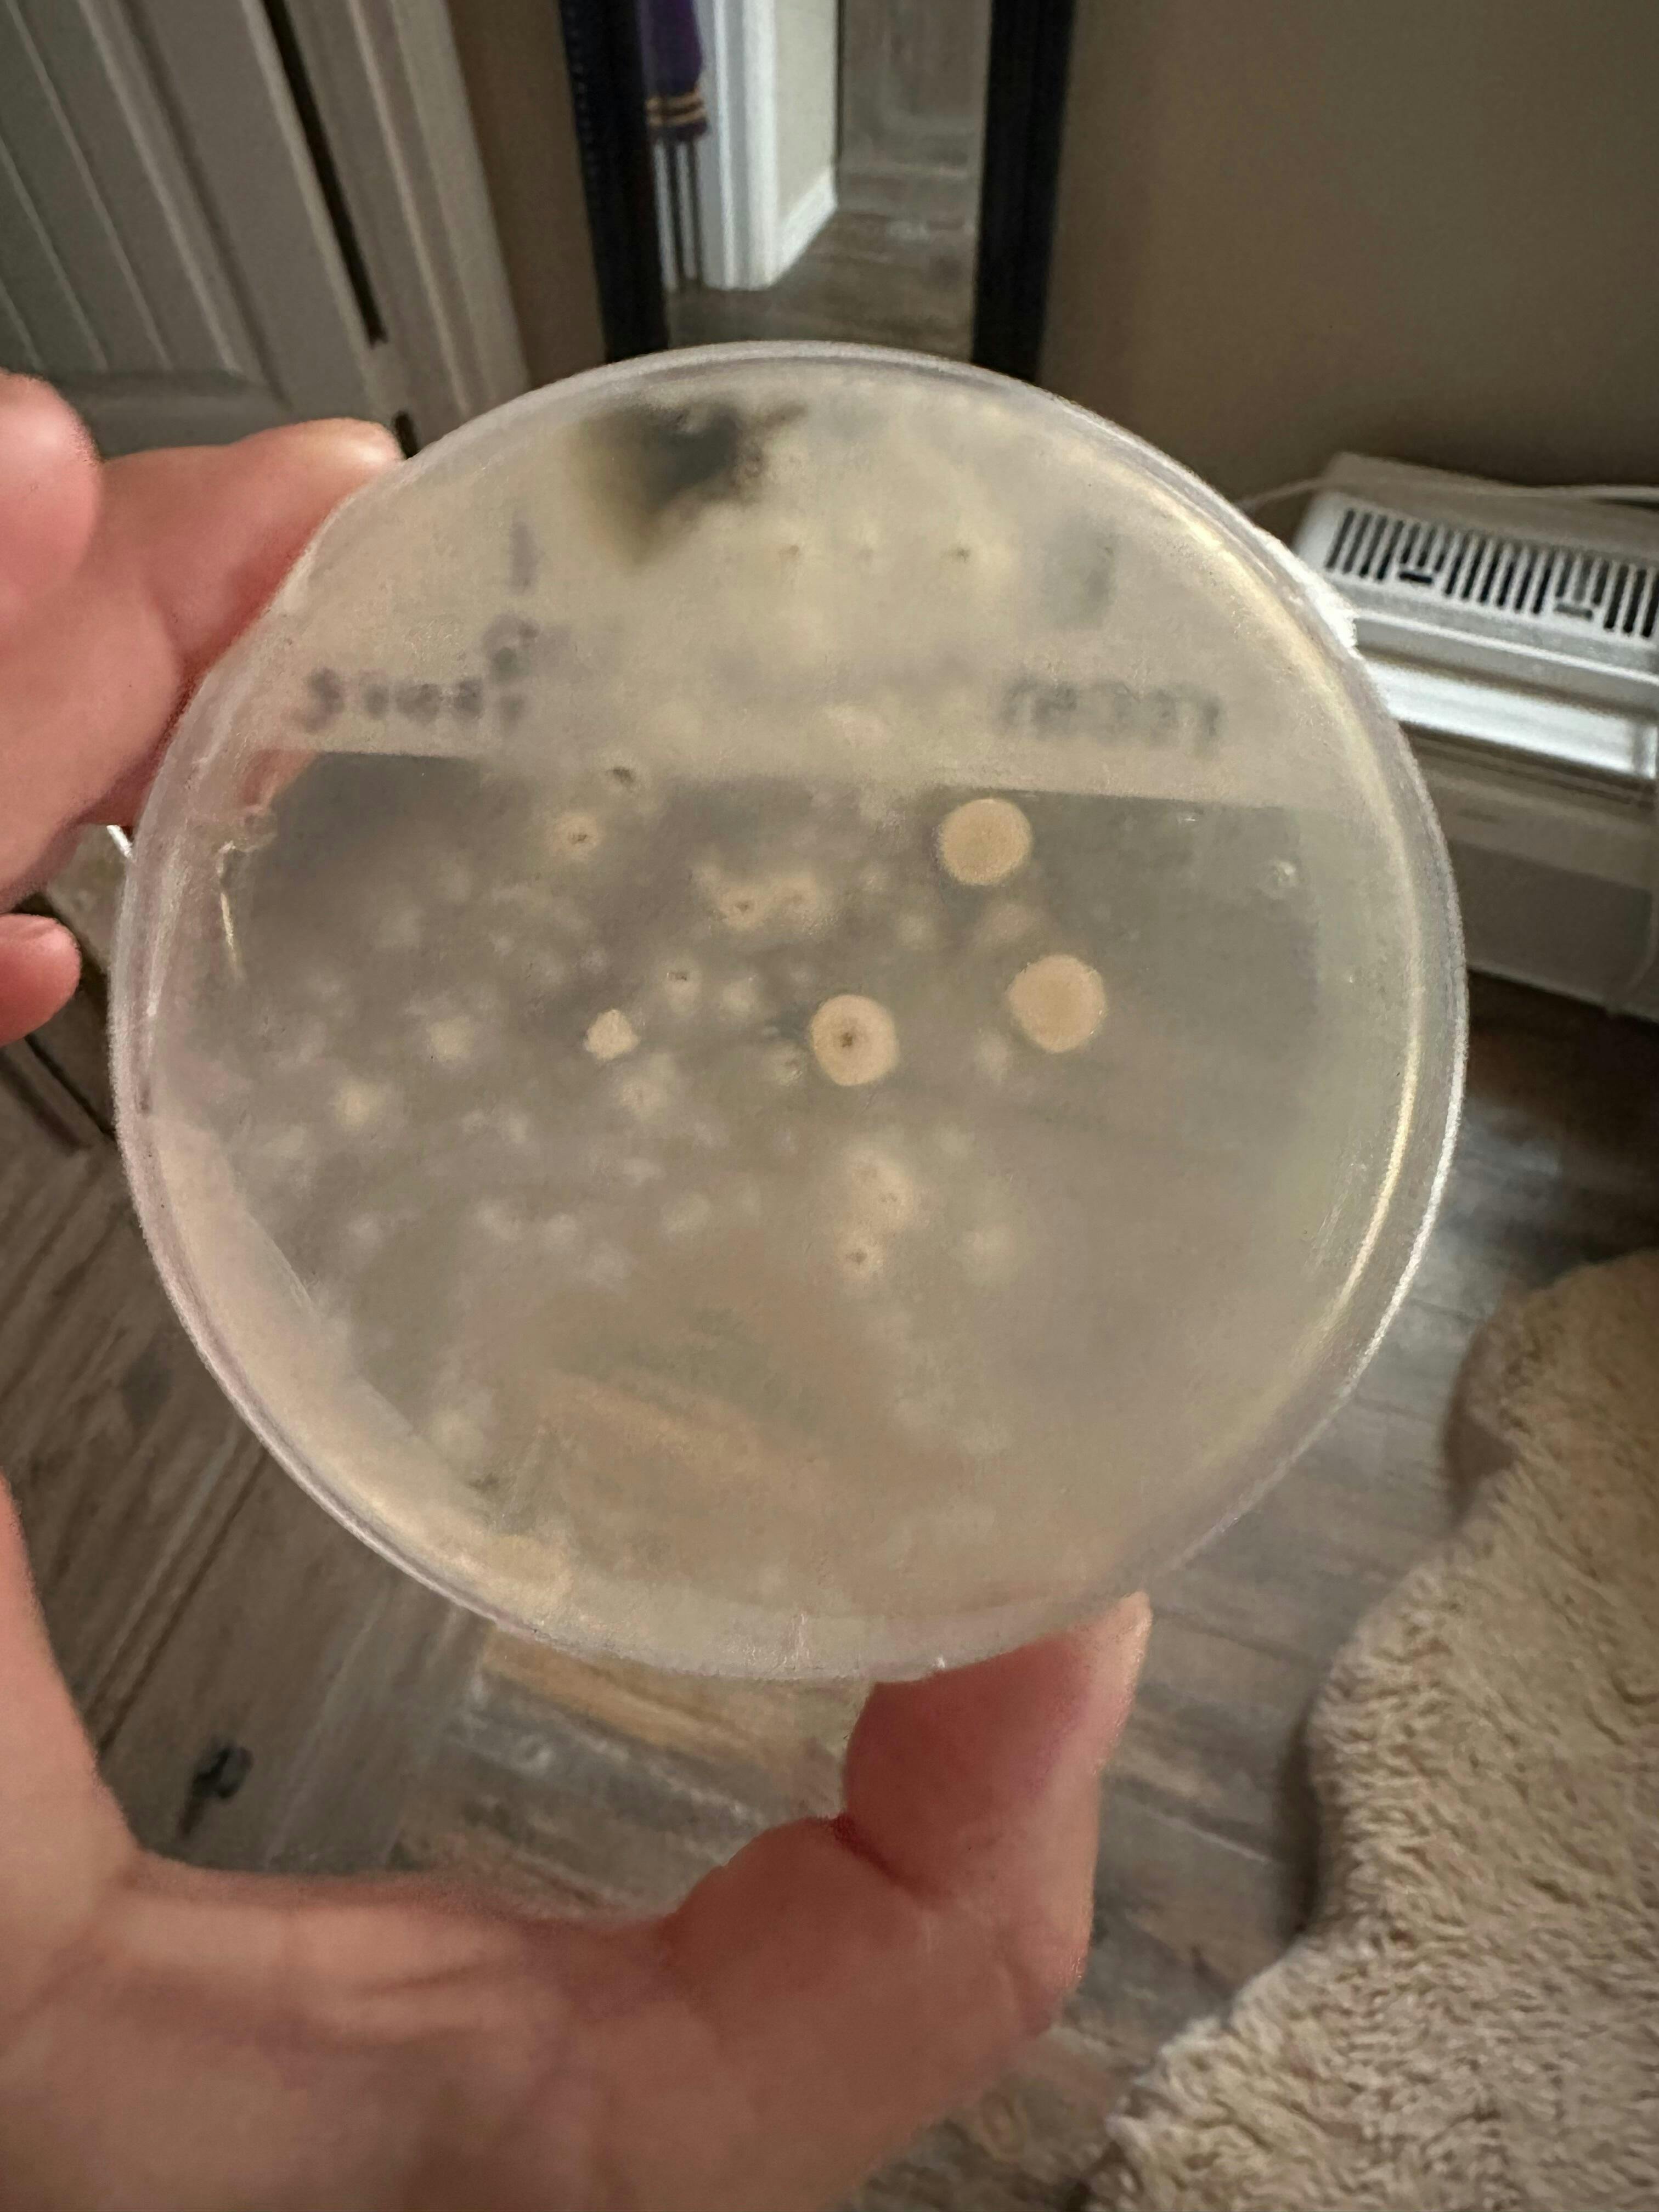

Blue Meanie Liquid Spores
Blue Meanie Liquid Spores
Couldn't load pickup availability
Blue Meanie Liquid Spores
Blue Meanie Liquid Spores Review
Recognized as one of the most potent hallucinogenic mushrooms ever to be shared in published research, Blue Meanie Mushroom Spores has a vibrant history and future that leaves significant interest and exploration. With its mature fruiting bodies and renewed flushes, it has become one of the most popular and sought-after species to exist.
What are Blue Meanie Liquid Spores? Blue Meanie Liquid Spores are spore syringes that contain spores of Psilocybe cubensis mushrooms in a liquid medium. Panaeolus cyanescens, nicknamed Blue Meanie, is a strain that gained its name from the distinct blue bruising that occurs at even the slightest contact. While some cubensis mushrooms have green or purple bruising, the blue bruising color is a clear indication that the strain contains high psilocybin content, which is why the research community continues to show great interest in this strain originating in southeastern Australia. When Blue Meanie is held in a liquid medium, it gives this interested party the ability to thoroughly study its hardiness. From inoculating agar plates, transforming grain into mushroom spawn, or creating an unlimited supply of liquid culture, Blue Meanie Liquid Spores is a study that many are ready to take on.
If you're ready to take on one of the most potent mushroom strains to exist, you'll find that its hardiness makes it a worthy subject for your next study session. This strain leads to medium, mature fruiting bodies and renewed flushes, alongside a powerful psilocybin concentration.
Features and Specifications
- Psilocybe Cubensis
- Southeastern Australia Origins
- Blue Meanie Strain
- Recommended For Spore Researchers
- Contains 10cc of Blue Meanie Liquid Spores
- 1.5" 20 Gauge Sterile Dispensing Needle
Product Includes
- 1 x Blue Meanie Liquid Spore 10cc Syringe
Share






So far, I took a small sample and placed the liquid culture on MEA agar to see how healthy the mycelium is before inoculation. I have only had bread mold, yeast, and cobweb mold growth and no mycelium growth. I used aseptic techniques but cannot confirm that my agar was sterile as I purchased them on line as well. However, I am seriously questioning the sterility of the genetic material. I went ahead and inoculated a grow bag to see what happens despite my initial results. I will return to update if/when I can identify the source of contamination. If my grow bag proceeds with healthy mycelium, I will blame my agar plates and/or possible flaws in my aseptic transfer techniques.
Sterile spores right from rip I used it in a lc !!!!!!!!already tested the syrenge on agar perfection!!!!!
Packaging nice. Syring came with alcohol wipe. Inoculated good in sterilized grain bag. Still unsure about the pheno/genetics. Time will tell.
I've tried so many but I always come back to the Blue Meanie. Thanks MSL for the great customer service when I made a mistake on my shipping address and it was fixed immediately. Got my order fast!! Happy girl
I placed my order for the 1st time and quickly received an email which I had a question and customer service made me at ease and I received my order in 4 days across the country. Ty about to start my research.